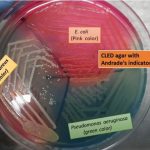
CLED Medium: Introduction, Uses,Composition, Preparation, Colony Characteristics, Modification and Limitations

Tag: CLED agar
Citrobacter werkmanii-Introduction, Morphology, Pathogenicity, Lab Diagnosis, Treatment, Prevention, and Keynote
 Introduction Citrobacter werkmanii is a gram-negative bacterium commonly found in...
Introduction Citrobacter werkmanii is a gram-negative bacterium commonly found in...
Serratia liquefaciens: Introduction, Morphology, Pathogenicity, Lab Diagnosis, Treatment, Prevention, and Keynotes
 Introduction Serratia liquefaciens is a Gram-negative bacterium that belongs to...
Introduction Serratia liquefaciens is a Gram-negative bacterium that belongs to...
CLED Medium: Introduction, Uses,Composition, Preparation, Colony Characteristics, Modification and Limitations
Introduction of CLED Medium CLED stands for cysteine, lactose, and...
Introduction of CLED Medium CLED stands for cysteine, lactose, and...
